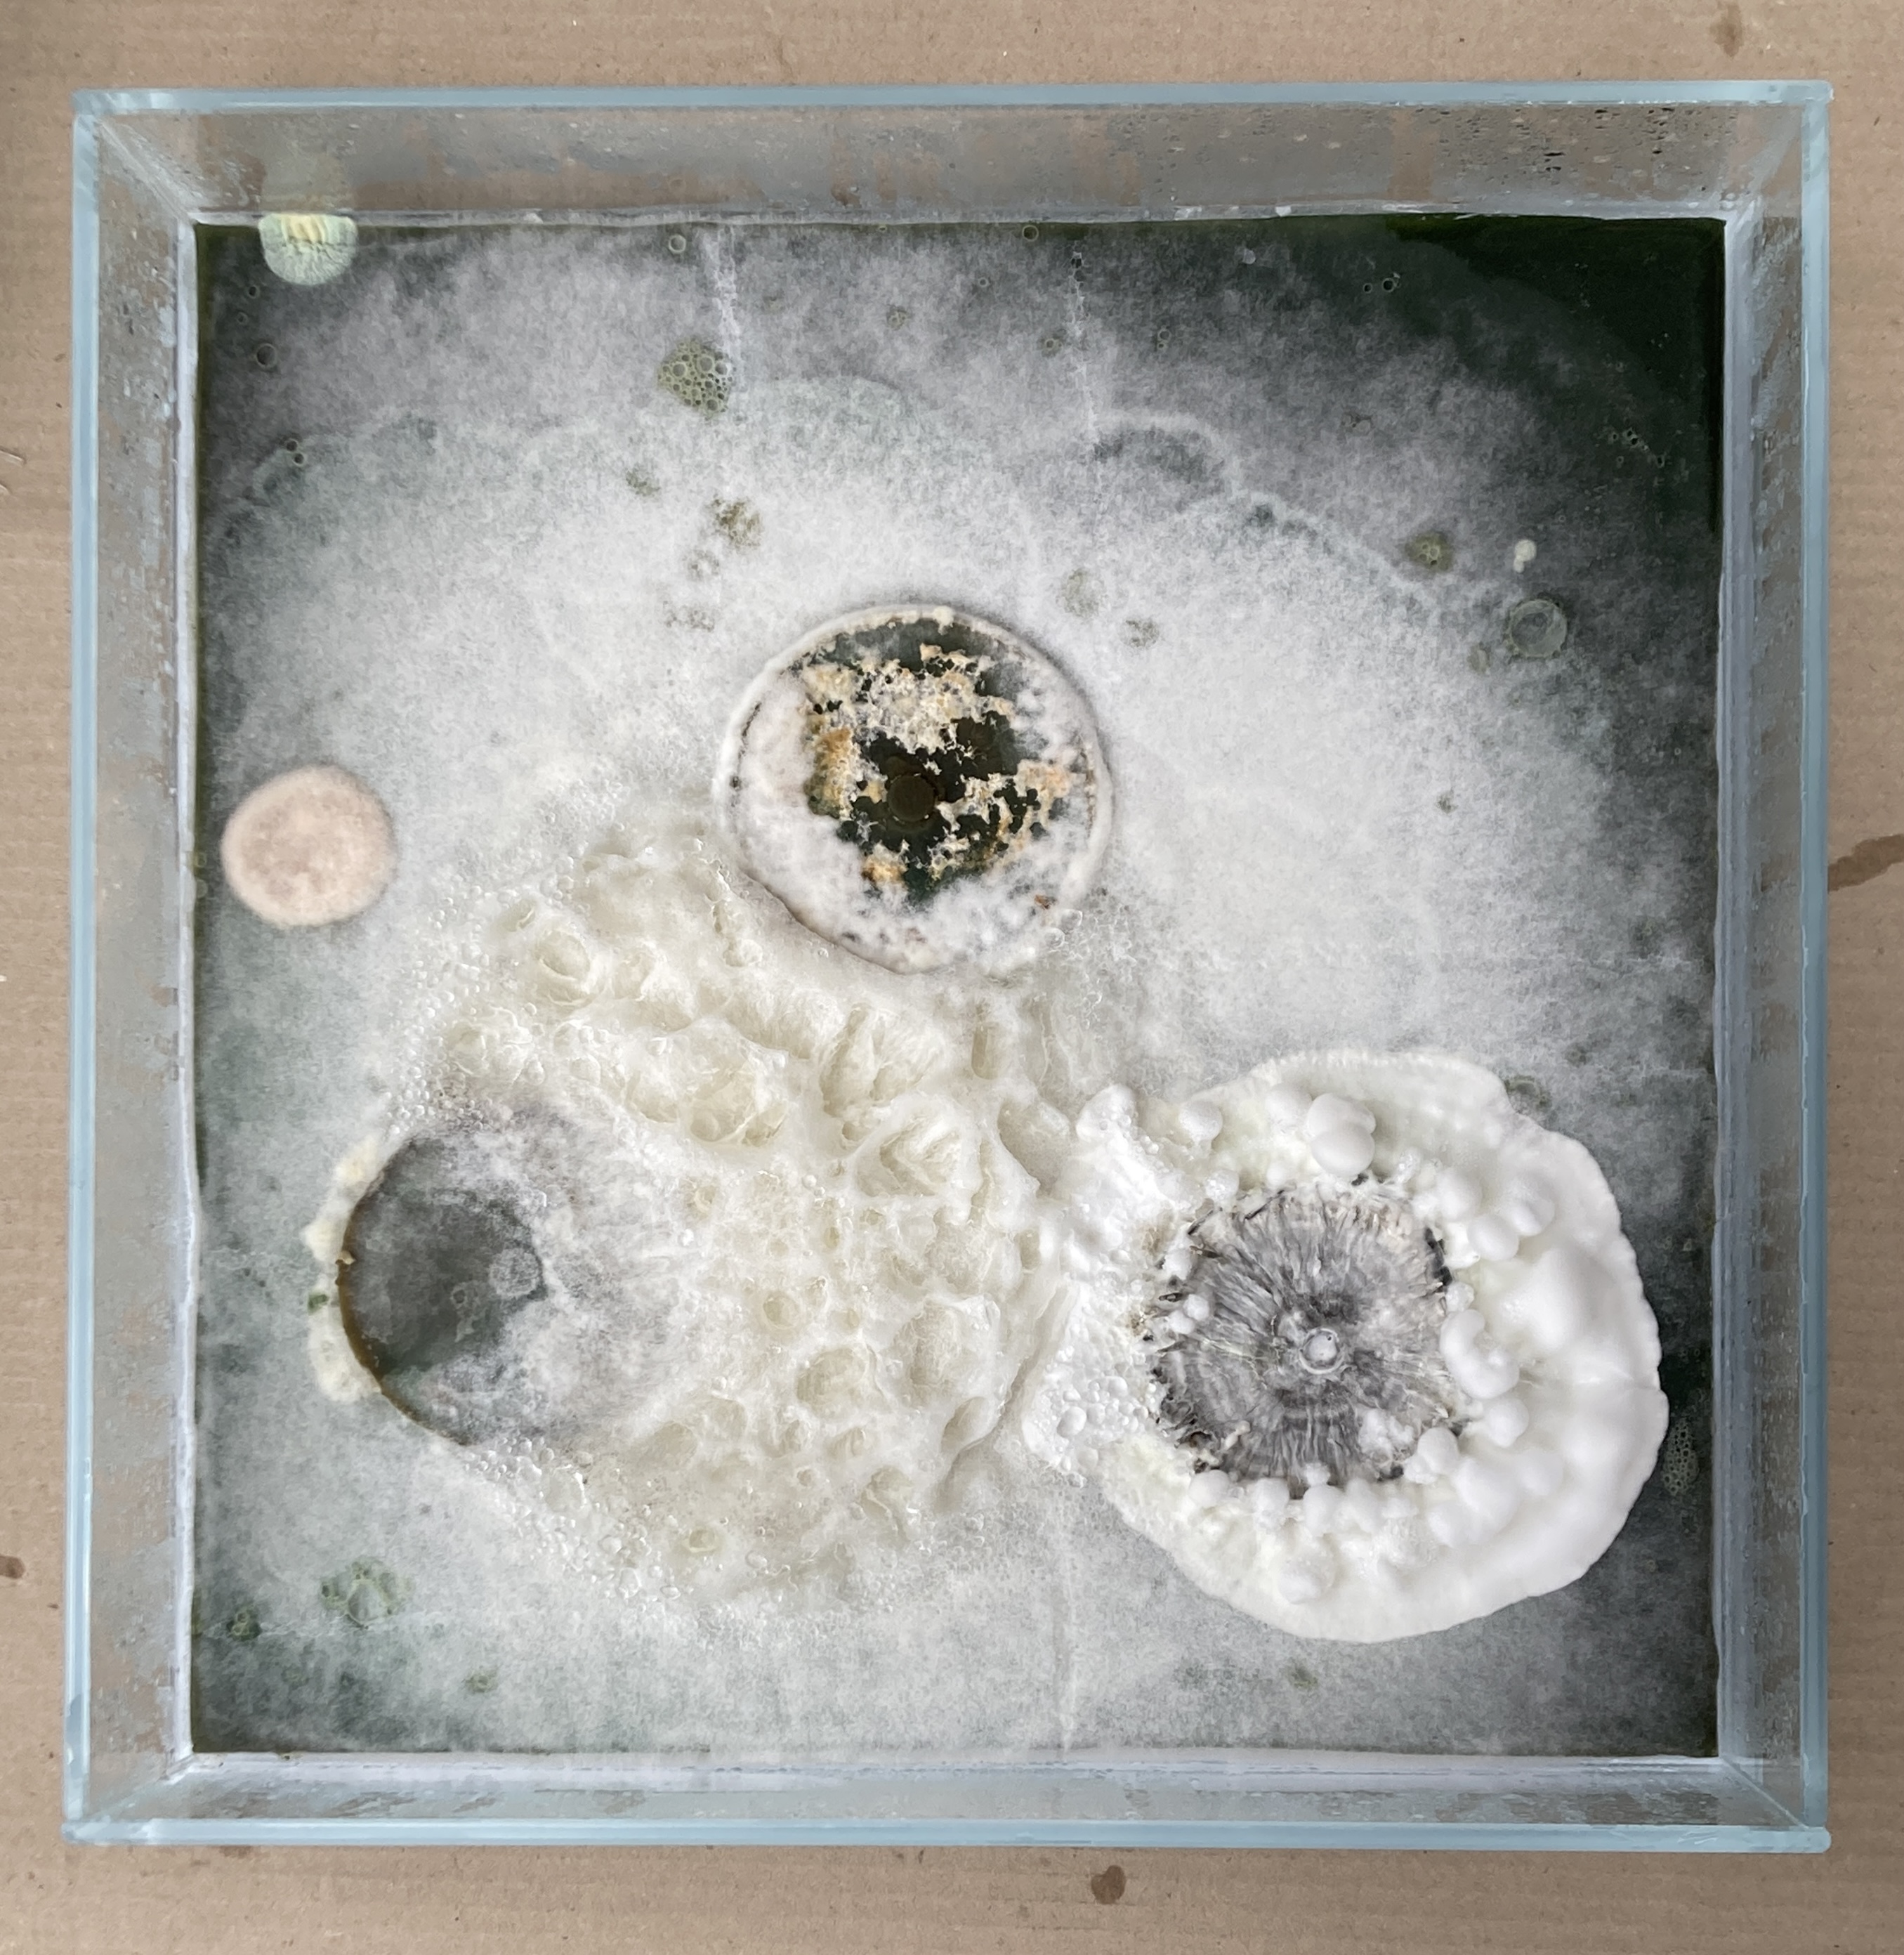
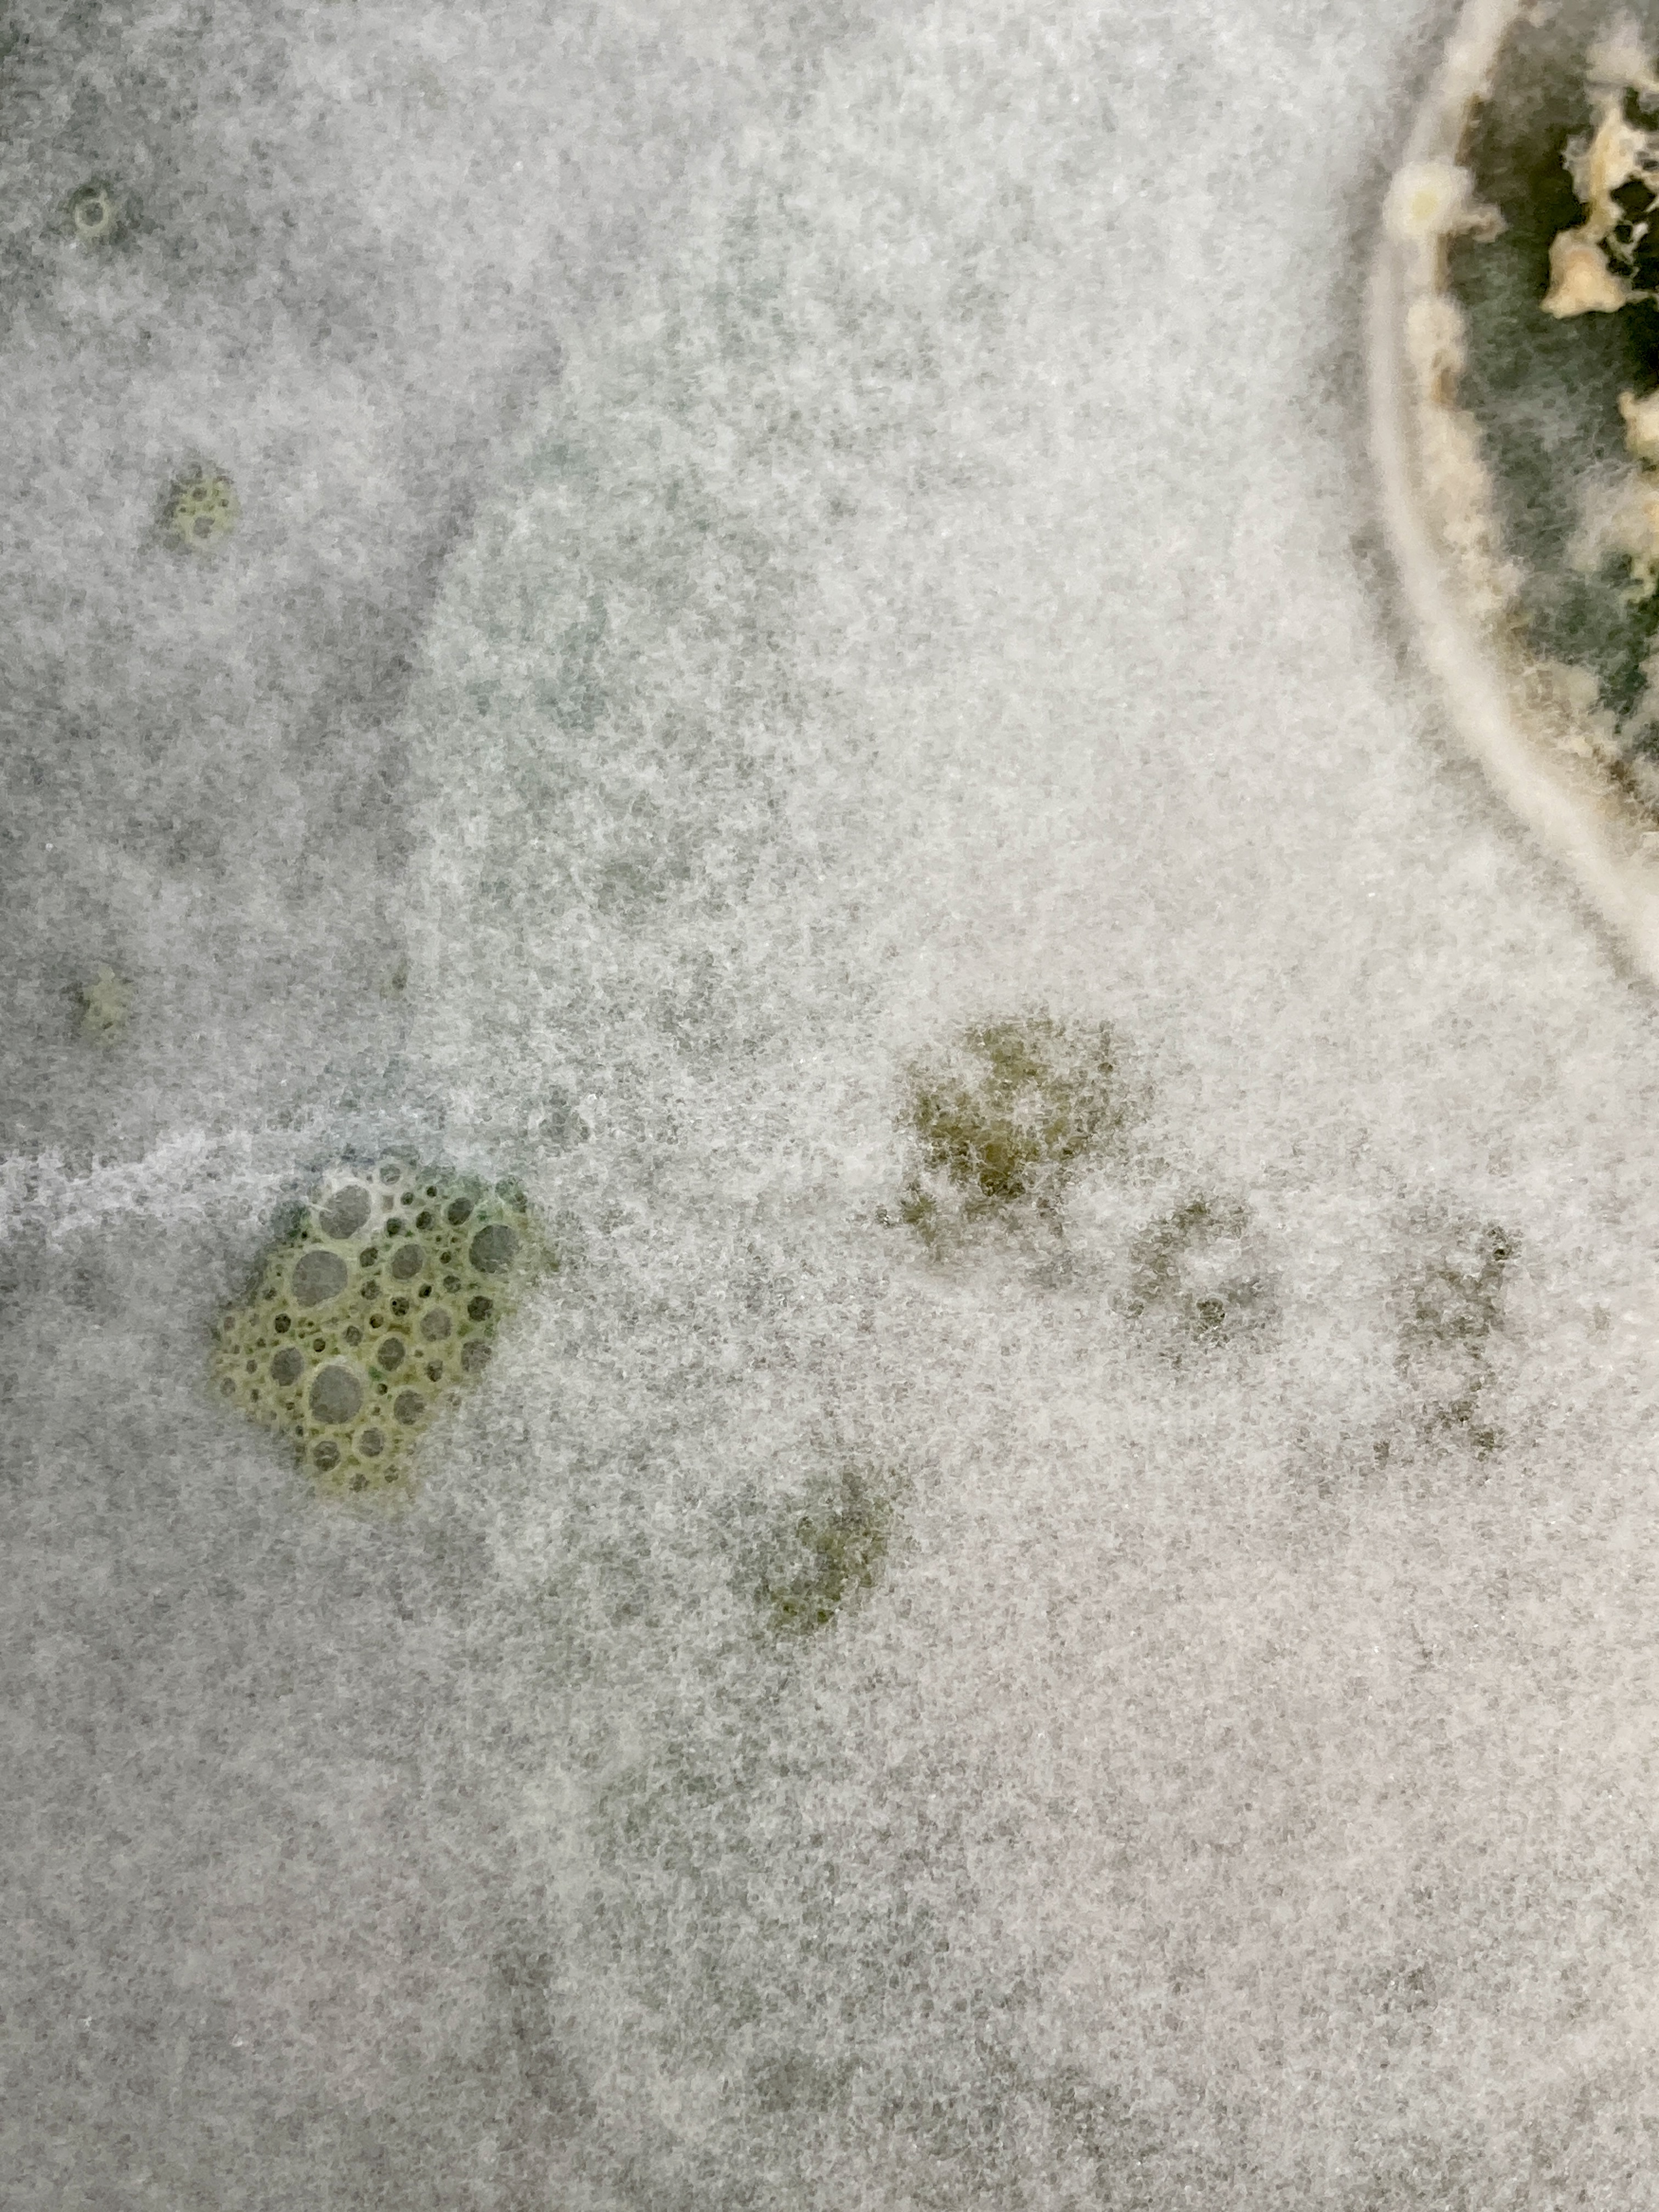
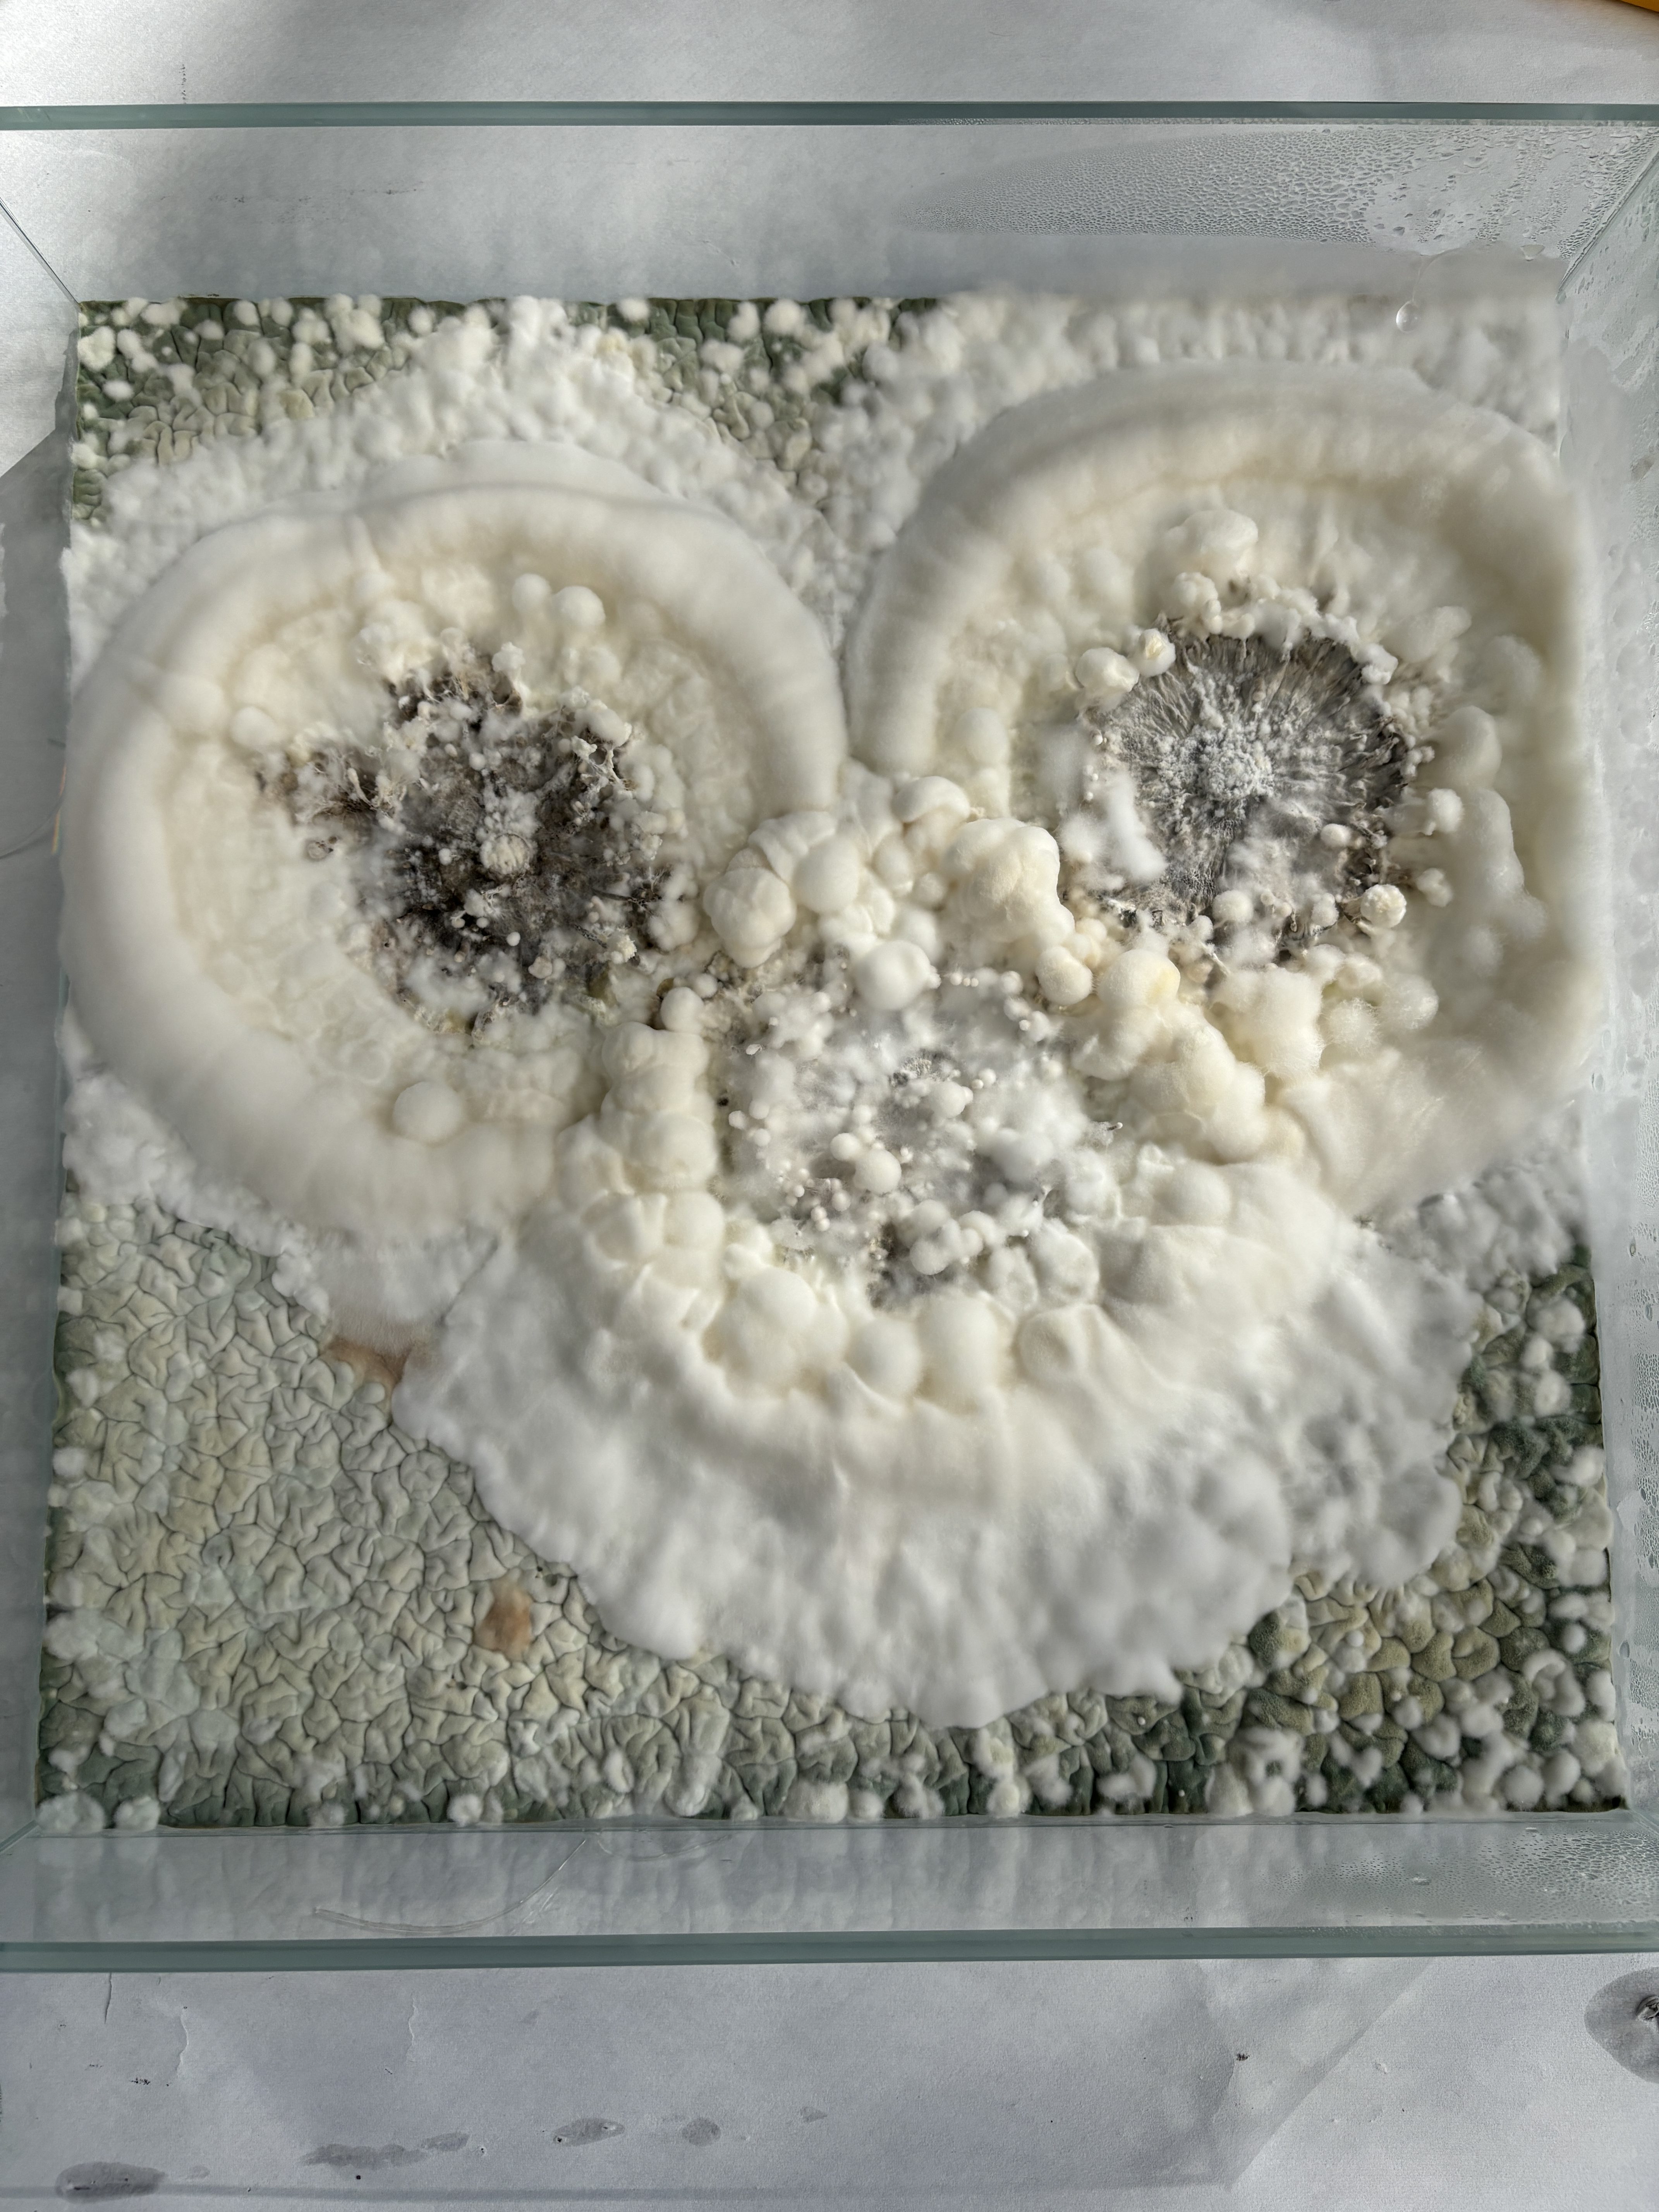

оон
Горизонтальні зв’язки | Horizontal links
В рамках науково-мистецької лабораторії у співпраці з мікологинею Алісою Атаманчук та виставки Serendipitous Events, організованої Port of Culture
- Термо-бокси для вирощування трьох різних видів міцелію
- Двоканальне відео
- Інсталяція з елементами міцелію
EN
Mycologist Alisa Atamanchuk & Alena Kuznetsova artist within the Serendipitous Events science art laboratory and show by Port of Culture
- Heated grow boxes with mycelium
- Two-channel video
- Installation with mycelium elements.
Питання, чи є “горизонтальною” українська мистецька та наукова спільнота, виявилось доволі дискусійним, адже навряд чи можна уявити повну відсутність конкуренції та мізогінії у цих сферах. Здатність підтримувати зв’язок і обмінюватися ресурсами та ідеями, коли колеги продовжують залишатися частиною єдиного «організму», дає можливіть для виживання і розвитку. Прикладом живої мережі, що функціонує як цілісний організм, є міцелій.
За втіленням принципу ризоми – мережевої децентралізованої системи, яка адаптується до змін і постійно формує нові зв’язки, міцелій у природі та горизонтальні зв’язки у соціумі – це нелінійні структури, які забезпечують взаємодію, обмін ресурсами і виживання в складних середовищах. Такий спосіб обміну інформацією між різними елементами однієї системи нагадує про їх взаємопов’язаність і акцентує множинність і відкритість до нових з’єднань. Чи можуть принципи таких гнучких систем втілюватись у суспільстві на заміну уявленням про лінійні й ієрархічні структури?
Чи може ця мрія стати реальністю нашого суспільства тут і тепер? Які умови потрібні для того, щоб люди не змагались, а колаборували, ділилися досвідом? Лабораторія Випадкові Події, як втім і деякі інші мистецькі резиденції, – була прикладом такої утопії, де, хоч і на доволі короткий термін, мисткині і науковиці мали спільну мету, однаковий для всіх ресурс (поживний ґрунт) і умови, де зароджувались нові взаємозв’язки та ідеї. Така собі багатовимірна структура, де всі точки взаємопов’язані і здатні до інтеграції.
En
The question of whether Ukraine’s artistic and scientific communities function as truly “horizontal” networks remains open to debate. It is difficult to imagine these fields being completely free of competition and misogyny. Yet, the ability to maintain communication, share resources, and exchange ideas — where colleagues function as part of a single “organism” — creates opportunities for both survival and growth. A compelling natural example of such a system is mycelium.
Embodied within the concept of the rhizome — a decentralized, networked system that constantly adapts and forms new connections — mycelium in nature, like horizontal connections in society, operates as a nonlinear structure. It facilitates interaction, resource exchange, and resilience in complex environments. The way information flows through such systems highlights their interconnectedness, multiplicity, and openness to new relationships.
Can the principles of these adaptive networks be applied to society, replacing rigid hierarchical structures with more fluid, cooperative ones? Can this vision become a reality here and now? What conditions are necessary for people to collaborate rather than compete, to share experiences instead of withholding them? The Laboratory of Serendipitous Events Initiative, along with other art residencies, has served as an example of such a utopian space — where, even if only briefly, artists and scientists shared a common goal, access to the same resources (a “fertile soil”), and conditions that fostered new relationships and ideas. It functioned as a multidimensional structure, where all points were interconnected and capable of integration.
Special thanks to the partners: Port of Culture, @_unfpa_ukraine, @euinua, @heforshe_ukraine,
at @ukrainskyi_dim
Special thanks to the partners: Port of Culture, @_unfpa_ukraine, @euinua, @heforshe_ukraine,
at @ukrainskyi_dim
Video, 13’48”
Research on mycelium growth during 2 weeks
Випадкові події | Serendipitous events
Преса | Press
Горизонтальні зв’язки | Horizontal links
Відкриття виставки | Opening evening
Photo: Port of Culture